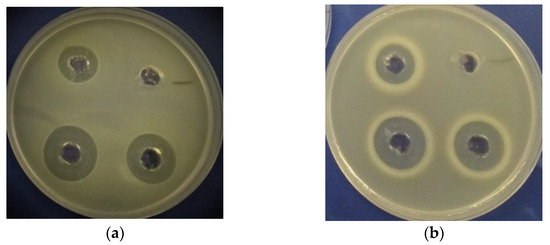

Abstract
Recently, there has been an increase in the application of lactic acid bacteria (LAB) for seed fermentation because of the improved functional, technological, and nutritional properties of the fermented seeds. The purpose of this study was to evaluate the effects of selected LAB on the biochemical and antimicrobial features of fermented hemp seeds and their water-, salt-, and ethanol-soluble protein fractions. The results showed that hemp seed medium was suitable for Lactiplantibacillus plantarum, Levilactobacillus brevis, and Lactobacillus acidophilus multiplication (with a LAB count > 109 colony-forming units/g). The biochemical and antimicrobial properties of the fermented hemp seeds strictly depended on the LAB strain used for fermentation. The hemp seeds fermented with L. brevis, which was previously isolated from rye sourdough, presented the highest total phenolic content and phytase, amylase, protease, and antioxidant activities. The hemp seeds fermented with L. acidophilus showed the broadest spectrum of antimicrobial activity against foodborne pathogens. The ethanol-soluble protein fractions from the fermented hemp seeds inhibited the growth of Escherichia coli, Staphylococcus aureus, Salmonella typhimurium, Bacillus subtilis, and Bacillus cereus, while the ethanol-soluble protein fraction from unfermented hemp seeds did not have an antimicrobial effect. The results of ABTS·+ radical scavenging and antimicrobial activity assays by agar well diffusion method confirmed that the tested LAB strains for hemp seed fermentation influenced the antioxidant and antimicrobial activities of protein fractions.
1. Introduction
Plant-based protein products are increasingly being incorporated into a wide range of foods and beverages to enhance their biological value. While proteins of animal origin provide a broader spectrum of amino acids, plant-based alternatives are gaining consumer attention due to the rise in vegan and vegetarian diets, as well as for reasons related to sustainability and health benefits. These changes have driven the food industry to develop more of these products [1]. Hemp (Cannabis sativa L.) proteins are particularly notable for their digestibility and balanced amino acid profile [2,3]. Furthermore, hemp proteins contain significantly more free sulfhydryl groups compared with proteins from other plants, such as soy [4]. Thanks to their favourable technological properties, they are ideal for enriching standard food formulations [5]. However, the processes used to extract protein derivatives, such as concentrates and isolates, can result in variable product quality, affecting both their nutritional value and functional characteristics [4,6].
To enhance the functional and nutritional properties of some proteins, enzymatic hydrolysis or fermentation by lactic acid bacteria (LAB) is commonly employed [7]. However, the fermentation process induces nutritional and biochemical changes in raw materials, making it difficult to further formulate food products [8,9].
Although some studies have examined lacto-fermentation in plant-based foods in recent years, there is still limited information on how protein properties change during the fermentation of hemp-derived ingredients [9,10,11]. Hemp seed products, especially hemp proteins, are increasingly regarded as valuable functional ingredients due to their excellent nutritional profile, favourable techno-functional properties, and bioactive compounds with health benefits [12]. Pontonio et al. [13] showed that LAB fermentation using Leuconostoc mesenteroides was the best method to significantly improve the antioxidant potential of hemp through intense proteolysis. It led to the release of bioactive peptides and an increase in protein digestibility. However, data about the influence of other LAB strains, especially isolated from sourdough, on the antioxidant and antimicrobial activity of fermented hemp seeds and hemp protein fractions are lacking. Understanding how fermentation influences the antioxidant and antimicrobial properties of hemp seed proteins and their fractions could provide useful insights for developing new food products with targeted bioactivity.
The purpose of this study was to evaluate the influence of three LAB starter cultures—Lactobacillus acidophilus DSM 20079, Lactiplantibacillus plantarum MR24, and Levilactobacillus brevis R26, which were selected based on prior studies demonstrating their adaptability to plant-based substrates [14]—on the biochemical properties and antimicrobial activity of hemp seeds. These strains have shown promising potential to produce substantial amounts of lactic acid and bioactive compounds, contributing to improved nutritional quality of fermented products. The acidity, LAB viability, enzymatic and antioxidant activities, total phenolic content (TPC), and antimicrobial properties of fermented hemp seed products were analysed. Moreover, the TPC and antioxidant and antimicrobial activities of hemp seed albumins, globulins, and prolamins—hydrolysed and not hydrolysed with pepsin—were evaluated.
2. Materials and Methods
2.1. Microorganisms
L. acidophilus DSM 20079, L. plantarum MR24, and L. brevis R26 were cultured in DeMan, Rogosa, and Sharpe (MRS) broth (CM 0359, Oxoid Ltd., Basingstoke, Hampshire, UK) at 30 °C for L. plantarum MR24 and 37 °C for L. brevis R26 and L. acidophilus DSM 20079 for 24 h. L. plantarum MR24 and L. brevis R26 were isolated from rye sourdough. L. acidophilus DSM 20079 was purchased from Leibniz Institute DSMZ-German Collection of Microorganisms and Cell Cultures.
2.2. Fermentation of Hemp Seed Flour
Hulled hemp seeds were purchased from a local supermarket in Lithuania. They contained 7 g of carbohydrates, 0 g of sugars, 32 g of fat, 3.2 g of saturated fatty acids, 20 g of crude protein, and 0.1 g of salt. Hemp seeds were milled (Retsch ZM200, Haan, Germany) to a particle size of <500 μm. The flour was sterilised at 121 °C for 15 min to remove viable microorganisms. For fermentation, sterilised flour was mixed with sterile water to obtain a final moisture content of 30% (with water activity of 0.936 ± 0.002). A fresh overnight LAB culture (0.2%) was used for inoculation. The hemp seed/water medium was fermented with a single LAB strain at 30 °C (using L. plantarum MR24) or 37 °C (using L. brevis R26 or L. acidophilus DSM 20079) for 72 h. The LAB count; total titratable acidity (TTA); pH; D/L-lactate content; volatile acidity; TPC; and enzymatic, antioxidant, and antimicrobial activities in the fermented hemp seed products were analysed. Additionally, the TPC and antioxidant and antimicrobial activities of hemp seed protein fractions were evaluated.
2.3. Determination of the Characteristics of Fermented Hemp Seed Flour
The LAB count in the fermented hemp seeds was evaluated according to ISO 4833:2003 [15] with some modifications. MRS agar was used to determine the LAB count. The Petri plates were incubated at 30 °C (for L. plantarum MR24) or 37 °C (for L. brevis R26 and L. acidophilus DSM 20079) for 72 h under an anaerobic atmosphere (Sigma-Aldrich Co., St. Louis, MO, USA). The LAB count is expressed as colony-forming units (CFU)/g.
The TTA of the fermented hemp seed product was evaluated according to standard techniques [16]. A sample (10 g) was homogenised with water (90 mL) in a porcelain mortar. The TTA is reported as millilitres of 1 M NaOH solution required to neutralise a sample to a pH of 8.5 [16].
D/L-lactate was determined using an enzymatic test (K-DLATE 08/11, Megazyme Ltd., Wicklow, Ireland), according to the manufacturer’s instructions. The sample extract was prepared by mixing a fermented hemp seed sample (1 g) with water (80 mL), filtering this mixture through a piece of Whatman No. 1 filter paper (Sigma-Aldrich), and diluting it with water up to a final volume of 100 mL.
Volatile acidity was evaluated as described previously [14]. To evaluate volatile acidity, a fermented hemp seed sample (25 g) was transferred to a distillation flask with 2% sulfuric acid (7.5 mL) and water (50 mL). Distillation was carried out in a Behr S4 Distillation unit (Behr Labor-Technik GmbH, Düsseldorf, Germany) under a selected program (80% power, 540 s duration). A solution of 0.1 M NaOH was used to titrate the distillate to a pH of 8.5. The volume of 0.1 M NaOH solution required for neutralisation is expressed as millilitres of 1 M NaOH solution per 100 g of sample.
The antioxidant activity and the TPC of the fermented hemp seed samples are expressed as milligrams of Trolox equivalents (TEs) per 100 g of hemp seeds and as milligrams of gallic acid equivalents (GAEs) per 100 g of hemp seeds, respectively. For evaluation of the antioxidant activity and the TPC, fermented and unfermented hemp seed samples (0.5 g) were prepared in aqueous methanol (4 mL), incubated on a shaker for 15 h, and then filtered through a filter. Section 2.6 provides the details on the analyses.
2.4. Determination of Enzymatic Activities in the Fermented Hemp Seed Products
Amylase activity was evaluated by measuring the intensity of starch-iodine solutions, as described by Xiao et al. [17], with some modifications described by Cizeikiene et al. [18]. One unit of amylase can hydrolyse 1 mg of soluble starch into dextrins in 1 min at 30 °C and pH 7.0. Fermented hemp seeds were homogenised with Na2HPO4 buffer (0.1 M, pH 7.0) at a concentration of 0.1 g/mL and then filtered through Whatman No. 1 filter paper. The sample extract (1 mL) and a 1 mg/mL starch solution (1 mL; Sigma-Aldrich) were mixed. The control sample was Na2HPO4 buffer (1 mL) and a 1 mg/mL starch solution (1 mL). The blank was Na2HPO4 buffer (1 mL) and the sample extract (1 mL). The samples were incubated at 30 °C for 30 min; then, the reaction was stopped by adding 1 M HCl (0.5 mL), followed by a 1 M iodine solution (5 M KI and 5 M I2; 2.5 mL). The absorbance was measured at 580 nm.
Phytase activity was determined by combining the methods reported by Quan et al. [19] and Olstorpe et al. [20]. One unit of phytase liberates 1 μmol of phosphorus from potassium phytate (Sigma-Aldrich) in 1 min at 30 °C and pH 5.5. A fermented hemp seed sample (0.1 g/mL) was prepared in NaCOOCH3 buffer (0.2 M, pH 5.5). The reaction consisted of NaCOOCH3 buffer (0.8 mL) supplemented with 3 mM potassium phytate and the sample extract (0.2 mL). For the blank, NaCOOCH3 buffer (0.8 mL) was mixed with the sample extract (0.2 mL). The reaction was performed at 30 °C for 30 min. It was stopped by adding 10% trichloroacetic acid (1 mL). Afterwards, the reaction mixture (0.2 mL) was mixed with a colour reagent (1.6 mL)—10 mM (NH4)6Mo7O24∙4H2O:2.5 M H2SO4:acetone (ratio 1:1:2)—and the absorbance was measured at 355 nm after 20 min.
Cellulase activity was determined by assessing the total content of reducing sugars. One unit of cellulase releases 1 μmol of glucose from cellulose filter paper in 1 min at 30 °C and pH 4.8. A fermented hemp seed sample (0.1 g/mL) was prepared in citric buffer (0.05 M, pH 4.8) and then filtered. The reaction mix comprised the sample extract (0.1 mL), cellulose filter paper (1.0 × 6.0 cm2), and citric buffer (0.9 mL). For the blank, citric buffer (0.9 mL) was mixed with the sample extract (0.1 mL). The reaction was performed at 30 °C for 30 min. Afterwards, the reaction mixture (1 mL) was mixed with 3,5-dinitrosalicylic acid (1 mL), boiled for 5 min in a water bath, and then cooled. The absorbance was measured at 540 nm.
Protease activity was measured using casein as a substrate [21]. One unit of protease is the amount of tyrosine (μmol) liberated from casein (Sigma-Aldrich) in 1 min at 37 °C and pH 7.5. A fermented hemp sample (0.1 g/mL) was homogenised in NaCOOCH3 buffer (10 mM, pH 7.5) supplemented with 5 mM CaCl2 and then filtrated. The sample extract (1 mL) and 0.65% casein solution (5 mL, pH 7.5) were mixed, and the reaction was performed at 37 °C for 10 min. Afterwards, the enzymatic reaction was inactivated by adding 110 mM trichloroacetic acid solution (5 mL). For the blank, the sample extract (1 mL) was added immediately after the trichloroacetic acid solution. Then, the test tubes were incubated at 37 °C for 30 min. Afterwards, a 0.45-µm polyethersulfone syringe filter (Sigma-Aldrich) was used to filter the solution. Then, filtrate (2 mL) was mixed with 0.5 M Na2CO3 (5 mL) and 0.5 M Folin–Ciocalteu reagent (1 mL; Sigma-Aldrich), incubated for 30 min, and filtered. The absorbance was measured at 660 nm.
2.5. Isolation and Hydrolysis of Protein Fractions from Hemp Seeds
2.5.1. Defatting of Hemp Seed Samples for Isolation of Protein Fractions
For protein fraction isolation, fermented hemp seed products were dried in a drying oven (Mechanical Convection, Thermo Fisher Scientific, Waltham, MA, USA) at 30 °C overnight. Unfermented hemp seed flour was used as a control sample. First, fermented and unfermented hemp flour was defatted according to Elsohaimy et al. [22], with slight modifications. Triple chloroform:methanol (2:1, v/v) extraction was carried out. The hemp seed sample was mixed with a chloroform:methanol solution (1:5, w/v) at 23 °C for 2 h on a shaker (KS 130, IKA, Staufen, Germany). After the final extraction, the chloroform:methanol solution was removed and the rest was evaporated in a fume hood at 23 °C for 16 h. The defatted samples were used to isolate protein fractions according to their solubility in different solvents: water, salt solution, and ethanol.
2.5.2. Isolation of the Water-Soluble Protein Fraction
The water-soluble protein fraction was isolated according to Elsohaimy et al. [22], with slight modifications. The defatted hemp seed product was mixed with distilled water (1:20, w/v). The pH of the sample was adjusted to 10 using 0.1 M NaOH. The mixture was stirred for 1.5 h while maintaining the pH at 10 to maximise protein solubilisation. After this incubation, the mixture was centrifuged (6000 rpm, 4 °C, 15 min) and the supernatant was collected. Then, 1 M hydrochloric acid was added to the supernatant using continuous stirring until the pH reached 4.5. Precipitated proteins were collected using centrifugation (8000 rpm, 4 °C, 30 min), frozen at −18 °C, freeze-dried (ZIRBUS Sublimator 3 × 4 × 5, Bad Grund, Germany), and stored at −18 °C.
2.5.3. Isolation of the Salt-Soluble Protein Fraction
The protein fraction soluble in 0.8 M NaCl was isolated as described by Hadnađev et al. [23], with some modifications. Defatted hemp seed flour was mixed with 0.8 M NaCl solution (pH 7.0) at a ratio of 1:10 (w/v), stirred at 23 °C for 2 h, and centrifuged (6000 rpm, 4 °C, 10 min) using 10-kDa membranes (Amicon Ultra, Merck Millipore, Burlington, MA, USA). The precipitates were washed twice with distilled water and centrifuged using 10-kDa membranes. The protein pellets were frozen at −18 °C, freeze-dried (ZIRBUS Sublimator 3 × 4 × 5), and stored at −18 °C.
2.5.4. Isolation of the Ethanol-Soluble Protein Fraction
The defatted hemp seed product was mixed with 70% ethanol (1:5, w/v), stirred at 23 °C for 5 h, and filtered through Whatman No. 1 filter paper according to Siddeeg et al. [24]. Ethanol was removed using a rotary evaporator (RV 10 Basic, IKA) at 170 rpm and 40 °C. After evaporation, the liquid was frozen at −18 °C, freeze-dried (ZIRBUS Sublimator 3 × 4 × 5), and stored at −18 °C.
2.5.5. Hydrolysis of the Protein Fractions with Pepsin
The water-, salt-, and ethanol-soluble protein fractions were hydrolysed with pepsin according to Siddeeg et al. [24]. The freeze-dried fractions were dissolved in water (pH 2, adjusted using 1 M HCl) to a final concentration of 1% protein. Pepsin (Sigma-Aldrich) solution (10 mg/mL) was prepared in water (pH 2). The prepared pepsin and protein solutions were mixed at a ratio of 1:100 (v/v). Hydrolysis was carried out at 37 °C for 3 h. Afterwards, pepsin was inactivated at 95 °C for 15 min in a water bath and then cooled; the pH was adjusted to 7. The hydrolysed and non-hydrolysed protein fractions were used for ABTS·+ radical scavenging assay and to determine the TPC and antimicrobial activity.
2.6. Determination of the Characteristics of Hemp Seed Protein Fractions
The ABTS·+ radical scavenging activity of the protein fractions (with and without enzymatic hydrolysis) was evaluated with a decolourisation assay according to Rajurkar and Hande [25]. The ABTS·+ cation radical was produced by mixing 2.45 mM potassium persulfate and 7 mM ABTS in water at a ratio of 1:1 (v/v) and incubating the solution in the dark at room temperature for 16 h. The ABTS·+ solution was diluted with methanol to obtain an absorbance of 0.700 at 734 nm. For the assay, 3.995 mL of the ABTS·+ solution was mixed with 5 µL of the protein fraction (10 mg/mL in distilled water) and incubated in the dark for 30 min. Then, the absorbance was measured at 734 nm. Trolox (0.05–1.00 mg/mL) was used as standard to obtain the calibration curve. The antioxidant activity in the protein fractions is expressed as mg TE per 100 g of protein.
The TPC of the protein fractions (with and without enzymatic hydrolysis) was determined using a modified Folin–Ciocalteu method [26]. A protein sample (100 µL of a 10 mg/mL solution [in distilled water]) was mixed with 3.3% sodium carbonate solution (3000 µL) and the Folin–Ciocalteu reagent (100 µL). The mixture was incubated at room temperature for 30 min, and then the absorbance was measured at 760 nm. Gallic acid (0.01–1.00 mg/mL) was used as standard to obtain the calibration curve. The TPC is expressed as mg GAE per 100 g of protein.
2.7. Determination of the Antimicrobial Activity
The antimicrobial activity against bacteria and fungi that cause food spoilage was evaluated by using the agar diffusion method described by Cizeikiene et al. [27], with slight modifications. The bacteria Staphylococcus aureus, Bacillus subtilis, Bacillus cereus, Escherichia coli, and Salmonella typhimurium were obtained from the collection of the Department of Food Science and Technology (Kaunas University of Technology). They were grown on Plate Count Agar (Biolife, Milan, Italy) in an incubator at 37 °C for 24 h. Bacteria were collected from agar slants after growing to prepare inocula containing ~108 cells/mL of bacteria using a McFarland 0.5 standard. In each Petri dish, 133 µL of the indicator strain suspension and 20 mL of soft Plate Count Agar were mixed carefully. The fungi Aspergillus versicolor, Penicillium chrysogenum, Penicillium cyclopium, Aspergillus terreus, and Penicillium sp. were obtained from the collection of the Institute of Botany of Nature Research Centre (Lithuania). They were grown on Potato Dextrose Agar (Biolife) at 25 °C for 3 days.
The antimicrobial activity of the hemp seed protein fractions (with and without enzymatic hydrolysis) against bacteria that cause food spoilage was also evaluated. In brief, 70 µL of each protein fraction (10 mg/mL in distilled water) were added to each well (with a diameter of 6 mm) that had been cut in the agar plates and incubated at 30 °C for 24 h. The antimicrobial activity of the protein fractions was evaluated by measuring the clear zone of inhibition in millimetres. Antimicrobial activity (the inhibition of bacteria growth around the well) was evaluated using the following scale: (−) no clear/growth inhibition zone around the well (no inhibition); (+/−) up to 1 mm clear/growth inhibition zone; (+) 1–3 mm clear/growth inhibition zone; (++) 3–5 mm clear/growth inhibition zone; and (+++) >5 mm clear/growth inhibition zone.
To evaluate the antimicrobial activity of fermented hemp seeds against bacteria and fungi that cause food spoilage, medium (20 mL) with a suspension of microorganisms (133 µL of the indicator strain suspension, as described above) was poured onto the fermented seeds, which were placed in the middle of a Petri dish. The plates were incubated at 30 °C for 24 h (for bacteria) or at 25 °C for 48 h (for fungi).
2.8. Statistical Analysis
STATISTICA 10.0 (StatSoft Corp., Krakow, Poland) was used for statistical analysis. Three independent replications were carried out for all experiments. The Duncan post-hoc test was used to determine whether there were significant differences in the variables between the control and analysed samples (p < 0.05).
3. Results and Discussion
3.1. Characteristics of the Fermented Hemp Seed Products
Table 1 presents the main characteristics regarding the efficiency of fermentation, namely the LAB count, pH, TTA, and acetic (volatile acidity) and lactic acid contents. Organic acids, primarily lactic and acetic acids, produced by LAB are the dominant metabolites that affect the acidity of the fermentation medium. These acids are known to play a crucial role in reducing pH, thereby influencing the bioactivity and antimicrobial properties of the fermented product. After fermentation for 48 h, the LAB count was > 109 CFU/g, confirming the suitability of hemp seed flour for LAB fermentation. The acidity of the fermented hemp seed products depended on the LAB strain used for fermentation. The hemp seeds fermented with L. plantarum presented the highest TTA and the lowest pH. The TTA of the hemp seed product fermented with L. plantarum was 79% higher than the TTA of the hemp seed product fermented with L. brevis and 32% higher than hemp seed product fermented with L. acidophilus. The TTA, pH, and LAB count results confirm the suitability of hemp seed flour for LAB propagation and for untraditional sourdough production, which can be applied for bread making. Nisa et al. [28] reported wheat sourdough with a higher pH (4.77–5.17) and a lower TTA (3.47–4.5 mL of 1 M NaOH) compared with the present study. Typically, the sourdough pH is <4.5, while the TTA strongly depends on the type of flour and the applied starter culture. Usually, the TTA of wheat sourdough is 8–13 mL of 1 M NaOH [29,30].

Table 1.
The characteristics of the hemp seeds after fermentation for 48 h.
During fermentation, carbohydrates are broken down to form lactic acid, which acidifies the media and thus reduces the pH. Unfermented hemp seed flour had the lowest lactic acid content and volatile acidity (which represents the acetic acid content). The mean lactic acid content of the fermented hemp seed products was 9.27–11.98 g/kg. This content is 2 times higher compared with the study by Robert et al. [31], who reported a lactic acid content of 3.0–5.5 g/kg in wheat sourdough produced with L. plantarum and Leuconostoc starters.
Fermentation with each tested LAB strain led to unique enzymatic changes of the fermented hemp seed product (Table 1). Fermentation with L. plantarum and L. brevis resulted in cellulase activity, while it was not observed in the unfermented hemp seed medium or after fermentation with L. acidophilus. The highest amylase, phytase, and protease activities were found after fermentation with L. brevis. Similarly, Songré-Ouattara et al. [32] found amylase and phytase activities in L. plantarum and L. fermentum strains isolated from fermented pearl-millet slurries. Phytase-producing LAB strains are especially preferred to produce wheat bread as well cereal and legume goods because of their ability to increase the nutritional quality by liberating inorganic phosphate and minerals [33,34]. Grains and seeds contain many minerals useful for human health—P, Mg, Fe, Cu, and Zn—but a large part of them are bound in complexes with phytic acid (phytates), which reduces the bioavailability of minerals. Phytase breaks down phytates, thereby increasing mineral absorption, and microorganisms such as yeast and LAB have been found to produce this enzyme [35].
During protein hydrolysis, microbial proteases lead to the formation of smaller peptides and subsequent degradation that releases free amino acids [36] and the formation of intermediates during the creation of aromatic products [37]. LAB are characterised by a complex proteolytic system, which mainly consists of cell wall-associated proteinases and intracellular peptidases, which break down peptides into amino acids [38]. Dallagnol et al. [38] reported on the protease activity during quinoa seed fermentation, including differences in protein mass. After fermentation with L. plantarum CRL 778 for 24 h, no 38 kDa proteins remained, while 22 kDa proteins were formed, which were not present before fermentation. After disrupting the cells of L. brevis and L. plantarum, various protein-degrading enzymes—proteases, endopeptidases, aminopeptidases, and dipeptidases—can be found in their extracts [39]. Cellulase activity is desirable to increase the efficiency of cellulose hydrolysis during fermentation to obtain a higher fermentable saccharide content and a higher content of primary metabolites of fermentation, including lactic and acetic acids as well as secondary metabolites.
The antioxidant activity of the fermented hemp seed products depended on the LAB strain. Fermentation with L. brevis increased the antioxidant activity up to 1.9 times, while fermentation with L. plantarum and L. acidophilus reduced the activity by 3.1 and 2.6 times, respectively. Other researchers have studied the effect of LAB fermentation on the antioxidant activity of seeds. In one study, the antioxidant activity of hemp seeds fermented with L. plantarum, L. brevis, and Lacticaseibacillus paracasei was up to 4 times higher compared with unfermented seeds [40]. Aloo et al. [41] found that fermentation of hemp seeds using Pediococcus acidilactici increased the antioxidant, anti-obesity, and anti-diabetic profile of hemp seeds.
Rizzello et al. [42] investigated the antioxidant properties of quinoa flour fermented with Lactobacillus strains; fermentation with L. plantarum increased the antioxidant activity. Ayyash et al. [43] fermented quinoa seeds with an L. plantarum strain and found a 2.5 times higher ABTS·+ radical scavenging ability after fermentation for 72 h compared with the control sample. The antioxidant activity was higher (1.3–1.4 times) after fermentation of lupine seeds using Latilactobacillus sakei, P. acidilactici, and Pediococcus pentosaceus compared with unfermented lupine seeds [44].
The TPC was increased in the hemp seeds fermented with L. plantarum, L. brevis, and L. acidophilus by 1.5, 5.0, and 2.0 times, respectively, compared with the unfermented hemp seeds. Other researchers have also reported that fermentation increases the TPC. Yoon et al. [40] reported a higher amount of polyphenolic compounds in fermented hemp seeds compared with unfermented seeds. Ayyash et al. [43] found that the TPC increased in quinoa seeds after fermentation with L. plantarum for 72 h, from 12 mg GAE/g (control) to 26 mg GAE/g. Krunglevičiūtė et al. [44] reported an 8–12% increase in the TPC after fermentation of lupine seeds using L. sakei, P. acidilactici, and P. pentosaceus.
3.2. Antimicrobial Activity of Hemp Seeds Fermented with LAB
The unfermented hemp seed flour did not exhibit antimicrobial activity against the tested bacteria and fungi, whereas after fermentation with LAB, there was antimicrobial activity against some foodborne pathogens (Table 2). The hemp seed product fermented with L. acidophilus presented the highest antimicrobial activity (against S. aureus, Salmonella typhimurium, B. subtilis, and B. cereus, with a clear inhibition zone of 3–5 mm). There was lower antimicrobial activity in the hemp seed product fermented with L. plantarum, with a clear inhibition zone of 3–5 mm for Salmonella typhimurium and 1–3 mm for E. coli, S. aureus, B. subtilis, and B. cereus. Finally, the hemp seed product fermented with L. brevis exhibited the lowest antimicrobial activity. The growth of A. versicolor was inhibited only by the hemp seeds fermented with L. plantarum, while Penicillium sp. growth was suppressed after fermentation with all three tested LAB strains, with a clear inhibition zone of 1–3 mm. The antimicrobial effect of hemp seeds fermented with L. acidophilus on the growth of Salmonella typhimurium is shown in Figure 1. A clear inhibition zone could be seen on the agar plates. The antimicrobial effect of LAB is mainly related to the production of lactic and acetic acids, as well as propionic, sorbic, and benzoic acids; hydrogen peroxide; and diacetyl, ethanol, phenolic, and proteinaceous compounds. Moreover, some LAB strains are able to synthesise antimicrobial substances (bacteriocins) [45]. Our findings agree with Yoon et al. [40] that during hemp seed fermentation with LAB strains, the antimicrobial substances produced and activity depend on the LAB strain.

Table 2.
The antimicrobial effect of hemp seeds fermented for 48 h on foodborne pathogens.

Figure 1.
A clear growth inhibition zone of Salmonella typhimurium on agar media is visible around the hemp seed products fermented with L. acidophilus DSM 20079.
3.3. Antimicrobial Activity of the Protein Fractions Isolated from Fermented Hemp Seeds
The effects of fermentation and enzymatic hydrolysis on the antimicrobial properties of protein fractions isolated from hemp seeds are presented in Table 3. The unfermented water-, salt-, and ethanol-soluble hemp seed protein fractions did not exhibit antimicrobial activity against E. coli, S. aureus, Salmonella typhimurium, B. subtilis, and B. cereus. However, when these protein fractions were hydrolysed with pepsin, they exhibited antimicrobial properties that depended on the LAB strain used for fermentation and the indicator microorganism.

Table 3.
The antimicrobial activity of the protein fractions isolated from hemp seed after fermentation with lactic acid bacteria and hydrolysis with pepsin.
The ethanol-soluble hemp protein fractions obtained after LAB fermentation presented antimicrobial activity. Specifically, they inhibited the growth of E. coli, S. aureus, Salmonella typhimurium, B. subtilis, and B. cereus, while the ethanol-soluble protein fraction of unfermented hemp seeds did not have an antimicrobial effect. The ethanol-soluble protein fraction extracted from hemp seeds fermented with L. acidophilus had the strongest antimicrobial activity. The antimicrobial effects of the non-hydrolysed and hydrolysed protein fractions soluble in 70% ethanol on the growth of some pathogens are shown in Figure 2.
Figure 2.
The antimicrobial effect of 70% ethanol-soluble hemp seed protein fractions obtained after fermentation with (a) L. plantarum MR24 on the growth of E. coli and (b) L. acidophilus on the growth of B. subtilis. A clear zone of inhibition around the ‘well’ indicates inhibition of the growth of food spoilage bacteria. Top: the effect of the non-hydrolysed protein fraction (left) and the control—blank sample (right). Bottom: the effect of two samples of hydrolysed protein fractions obtained after fermentation with LAB.
The non-hydrolysed salt- and water-soluble hemp protein fractions did not exhibit antimicrobial activity, whereas the same protein fractions hydrolysed with pepsin did. The salt-soluble and pepsin-hydrolysed protein fraction from hemp seeds fermented with L. brevis presented the strongest antimicrobial activity; it inhibited the growth of S. aureus, B. subtilis, and B. cereus.
Plant antimicrobial peptides create protection against microbial attacks of pathogens given their excellent structural stability, wide spectrum of activity, and diverse mechanism of action. Antimicrobial peptides are able to inhibit the transport of proteins, act as enzymes and steroid hormone regulators, and/or interact with DNA and RNA [46]. Plant antimicrobial peptides act differently from other antimicrobial peptides due to the abundance of cysteine residues and disulfide bridges [46,47]. These peptides are a part of the barrier defence mechanisms from the different parts of plants, including seeds [48]. Bioactive peptides obtained from food proteins, released by enzymatic hydrolysis or fermentation, can be employed as a natural alternative to antibiotics and as preservative agents due to their ability to inhibit the growth of several microorganisms [49]. Sharma et al. [50] described peptides with antimicrobial activity that could be used to prevent foodborne diseases and food spoilage. The antimicrobial effect of the protein fractions after hydrolysis with pepsin is due to the generation of bioactive peptides with an antimicrobial effect during hydrolysis. Yekta et al. [51] studied the antimicrobial activity of quinoa seeds and found that microbiological contamination (based on the S. aureus count) in meat products was lower with quinoa peptides. Mudgil [52] also examined quinoa seed peptides and their antimicrobial properties and found that the inhibitory zone against different bacteria (S. aureus, Salmonella typhimurium, E. coli, and Enterobacter aerogenes) was larger after enzymatic hydrolysis.
3.4. Antioxidant Activity and the THC Content in the Protein Fractions from Fermented Hemp Seeds
Table 4 shows the antioxidant activity of the non-hydrolysed and hydrolysed protein fractions obtained from unfermented and fermented hemp seeds, as well as of protein fractions hydrolysed with pepsin. The ethanol-soluble protein fractions showed a greater ABTS·+ radical scavenging ability compared with the water- and salt-soluble protein fractions. In all cases, hydrolysis with pepsin reduced the ABTS·+ radical scavenging ability. A high hydrophobic amino acid content has been associated with low solubility, which leads to low ABTS·+ radical scavenging activity [53].

Table 4.
The antioxidant activity (mg TE/100 g protein) and total phenolic content (GAE mg/100 g protein) of the protein fractions from hemp seeds after (i) fermentation with LAB and (ii) enzymatic hydrolysis with pepsin.
The water-soluble protein fractions from the fermented hemp seeds had higher antioxidant activity compared with the unfermented hemp seeds, while the antioxidant activity of the salt- and ethanol-soluble protein fractions depended on the LAB strain used for fermentation. Fermentation with L. acidophilus increased the ABTS·+ radical scavenging activity of the ethanol-, salt- and water-soluble protein fractions by 17%, 32%, and 98%, respectively, compared with the unfermented protein fractions. The non-hydrolysed ethanol-soluble protein fraction of hemp seeds fermented with L. acidophilus presented the highest ABTS·+ radical scavenging ability (91.1 mg TE/100 g of protein).
Girgih et al. [54] hydrolysed hemp seed protein isolates with pepsin and pancreatin and evaluated the antioxidant activity of the obtained hydrolysates using the DPPH free radical scavenging method. The hydrolysed protein fractions had up to 6 times higher antioxidant activity, depending on the molecular weight of the protein fraction. The hemp seed protein hydrolysates exhibited significantly weaker scavenging of DPPH radicals compared with the fractionated peptides. The protein fraction with the lowest molecular weight (<1 kDa) showed the highest antioxidant activity. The antioxidant properties of protein hydrolysates mostly depend on degree of hydrolysis, enzyme specificity, and the nature of the peptides released, including the molecular weight, amino acid composition, and hydrophobicity [55,56,57]. The antioxidant activity of most peptides increases with the presence of amino acids such as tyrosine, lysine, histidine, tryptophan, methionine, and proline [58]. Due to ability to reduce the risk of cancer and other chronic diseases, phenolic compounds have a positive effect on human health. Indeed, these compounds can bind to free radicals [59].
The ethanol-soluble protein fractions showed a higher TPC compared with water- and salt-soluble fractions. The water-soluble protein fractions extracted from fermented hemp seeds had a higher TPC compared with the unfermented seeds, while the TPC in the salt- and ethanol-soluble protein fractions depended on the LAB strain used for fermentation; in samples obtained from hemp seeds fermented with L. acidophilus, the TPC increased by 65% and 33%, respectively, while the ethanol-soluble protein fraction from hemp seeds fermented with L. plantarum presented a 48% reduction in the TPC.
Hydrolysis with pepsin increased the TPC in the water- and salt-soluble protein fractions by 8 and 2 times, respectively, while the TPC was reduced by 50% in the ethanol-soluble fraction of unfermented hemp seed flour. The TPC after hydrolysis with pepsin strongly depended on the LAB strain used for fermentation. The ethanol-soluble fractions obtained after fermentation with L. plantarum and L. acidophilus presented the highest TPC, 4.37 and 4.25 GAE mg/100 g protein, respectively.
Garcia-Mora et al. [60] isolated proteins from spotted beans, which were hydrolysed by alcalase and savinase. After hydrolysis for 120 min, the TPC increased by 2 and 2.3 times, respectively. This change was due to the higher amount of short bioactive peptides formed during hydrolysis. Chanput et al. [61] studied protein fractions isolated from rice bran and found that the TPC decreased after enzymatic hydrolysis; this could be due to the degradation of phenolic compounds during hydrolysis, as well as the high temperature (95 °C for 15 min) used to inactivate pepsin.
4. Conclusions
This study demonstrated that microbial fermentation is a promising method to significantly enhance the biochemical and antimicrobial potential of hemp seeds and their protein components. For hemp seed fermentation, the use of starter cultures such as L. acidophilus DSM 20079, L. plantarum MR24, and L. brevis R26 are recommended due to their adaptability to plant-based substrates and their capacity to effectively produce lactic acid and bioactive compounds. Among these, L. brevis R26 showed the most promise, exhibiting the highest levels of amylase, cellulase, phytase, and protease activities, as well as producing the highest TPC and antioxidant activity in the fermentation medium. Hemp seed flour fermented with L. brevis R26 could serve as a non-traditional sourdough starter for functional bread production. Additionally, proteins isolated from fermented hemp seed substrates could be used in developing new functional foods—such as protein-enriched bakery, confectionery, or dairy products—due to their enhanced antimicrobial and antioxidant properties. It should also be noted that other LAB strains may be viable for fermentation, each potentially offering unique advantages in terms of flavour, the nutritional profile, and functional attributes. Exploring additional LAB strains could be a valuable direction for future research. Furthermore, additional studies on the technological properties and digestibility of hemp proteins modified by lactic acid fermentation are recommended to facilitate their inclusion in new food formulations. Finally, the fermentation process described in the present study may also be applicable to other high-protein seeds, such as soy, sunflower, and pumpkin. Each seed type, however, has unique structural and compositional characteristics that could affect the selection of LAB strains and fermentation conditions. Hence, further research is warranted to optimise these variables for each seed type to expand the application of this method.
Author Contributions
Conceptualization, D.Č.; methodology, D.Č., I.G. and D.Ž.; software, I.G.; validation, I.G. and D.Ž.; formal analysis, L.B. and I.G.; investigation, I.G.; resources, D.Č.; data curation, D.Ž. and L.B.; writing—original draft preparation, I.G., D.Ž. and D.Č.; writing—review and editing, D.Ž., L.B. and D.Č.; visualization, I.G.; supervision, D.Č. All authors have read and agreed to the published version of the manuscript.
Funding
This research received no external funding.
Institutional Review Board Statement
Not applicable.
Informed Consent Statement
Not applicable.
Data Availability Statement
The data presented in this study are available in the article.
Conflicts of Interest
The authors declare no conflicts of interest.
References
- Lonnie, M.; Laurie, I.; Myers, M.; Horgan, G.; Russell, W.R.; Johnstone, A.M. Exploring health-promoting attributes of plant proteins as a functional ingredient for the fooFd sector: A systematic review of human interventional studies. Nutrients 2020, 12, 2291. [Google Scholar] [CrossRef] [PubMed]
- Hourfane, S.; Mechqoq, H.; Bekkali, A.Y.; Rocha, J.M.; El Aouad, N. A comprehensive review on Cannabis sativa ethnobotany, phytochemistry, molecular docking and biological activities. Plants 2023, 12, 1245. [Google Scholar] [CrossRef] [PubMed]
- Shen, P.; Gao, Z.; Fang, B.; Rao, J.; Chen, B. Ferreting out the secrets of industrial hemp protein as emerging functional food ingredients. Trends Food Sci. Technol. 2021, 112, 1–15. [Google Scholar] [CrossRef]
- Yano, H.; Fu, W. Hemp: A sustainable plant with high industrial value in food processing. Foods 2023, 12, 651. [Google Scholar] [CrossRef] [PubMed]
- van de Noort, M. Lupin: An important protein and nutrient source. In Sustainable Protein Sources, 2nd ed.; Nadathur, S., Wanasundara, J.P.D., Scanlin, L., Eds.; Academic Press: Boston, MA, USA, 2024; pp. 219–239. [Google Scholar]
- Tang, N.; Yang, G.; Ma, Y.; Liang, X.; Zhou, W. Hemp seed protein: A review of its application, functional properties, and biological activities. J. Funct. Foods 2021, 78, 104353. [Google Scholar]
- Wang, Y.; Wu, J.; Lv, M.; Shao, Z.; Hungwe, M.; Wang, J.; Bai, X.; Xie, J.; Wang, Y.; Geng, W. Metabolism characteristics of lactic acid bacteria and the expanding applications in food industry. Front. Bioeng. Biotechnol. 2021, 9, 612285. [Google Scholar] [CrossRef]
- Melini, F.; Melini, V.; Luziatelli, F.; Ficca, A.G.; Ruzzi, M. Health-promoting components in fermented foods: An up-to-date systematic review. Nutrients 2019, 11, 1189. [Google Scholar] [CrossRef]
- Sanlier, N.; Gokcen, B.B.; Sezgin, A.C. Health benefits of fermented foods. Crit. Rev. Food Sci. Nutr. 2019, 59, 506–527. [Google Scholar] [CrossRef]
- Yang, X.; Hong, J.; Wang, L.; Cai, C.; Mo, H.; Wang, J.; Fang, X.; Liao, Z. Effect of lactic acid bacteria fermentation on plant-based products. Fermentation 2024, 10, 48. [Google Scholar] [CrossRef]
- Nissen, L.; Casciano, F.; Babini, E.; Gianotti, A. The eploitation of a hmpseed byproduct to produce flavorings and healthy food ingredients by a fermentation process. Microorganisms 2021, 9, 2418. [Google Scholar] [CrossRef]
- Crini, G.; Lichtfouse, E.; Chanet, G.; Morin-Crini, N. Applications of hemp in textiles, paper industry, insulation and building materials, horticulture, animal nutrition, food and beverages, nutraceuticals, cosmetics and hygiene, medicine, agrochemistry, energy production and environment: A review. Environ. Chem. Lett. 2020, 18, 1451–1476. [Google Scholar] [CrossRef]
- Pontonio, E.; Verni, M.; Dingeo, C.; Diaz-de-Cerio, E.; Pinto, D.; Rizzello, C.G. Impact of Enzymatic and microbial bioprocessing on antioxidant properties of hemp (Cannabis sativa L.). Antioxidants 2020, 9, 1258. [Google Scholar] [CrossRef] [PubMed]
- Cizeikiene, D.; Gaide, I.; Basinskiene, L. Effect of lactic acid fermentation on quinoa characteristics and quality of quinoa-wheat composite bread. Foods 2021, 10, 171. [Google Scholar] [CrossRef] [PubMed]
- ISO 4833; Microbiology of Food and Animal Feeding Stuffs—Horizontal Method for the Enumeration of Microorganisms—Colony-Count Technique at 30 °C. International Organization for Standardization: Geneva, Switzerland, 2003.
- AACC. Approved Methods of the American Association of Cereal Chemists, 10th ed.; AACC International: St. Paul, MN, USA, 2000. [Google Scholar]
- Xiao, Z.; Storms, R.; Tsang, A. A quantitative starch-iodine method for measuring alpha-amylase and glucoamylase activities. Anal. Biochem. 2006, 351, 146–148. [Google Scholar] [CrossRef]
- Cizeikiene, D.; Jagelaviciute, J.; Stankevicius, M.; Maruska, A. Thermophilic lactic acid bacteria affect the characteristics of sourdough and whole-grain wheat bread. Food Biosci. 2020, 38, 100791. [Google Scholar] [CrossRef]
- Quan, C.S.; Fan, S.D.; Mang, L.H.; Wang, Y.J.; Ohta, Y. Purification and properties of a phytase from Candida krusei WZ-001. J. Biosci. Bioeng. 2002, 94, 419–425. [Google Scholar]
- Olstorpe, M.; Schnurer, J.; Passoth, V. Screening of yeast strains for phytase activity. FEMS Yeast Res. 2009, 9, 478–488. [Google Scholar] [CrossRef]
- Cupp-Enyard, C. Sigma’s non-specific protease activity assay—Casein as a substrate. J. Vis. Exp. 2008, 19, 899. [Google Scholar] [CrossRef]
- Elsohaimy, S.A.; Refaay, T.M.; Zaytoun, M.A.M. Physicochemical and functional properties of quinoa protein isolate. Ann. Agric. Sci. 2015, 60, 297–305. [Google Scholar] [CrossRef]
- Hadnađev, M.; Dapčević-Hadnađev, T.; Lazaridou, A.; Moschakis, T.; Michaelidou, A.M.; Popović, S.; Biliaderis, C.G. Hempseed meal protein isolates prepared by different isolation techniques. Part I. Physicochemical properties. Food Hydrocoll. 2018, 79, 526–533. [Google Scholar] [CrossRef]
- Siddeeg, A.; Xu, Y.; Jiang, Q.; Xia, W. In vitro antioxidant activity of protein fractions extracted from seinat (Cucumis melo var. Tibish) seeds. CyTA-J. Food 2015, 13, 472–481. [Google Scholar] [CrossRef][Green Version]
- Rajurkar, N.S.; Hande, S.M. Estimation of phytochemical content and antioxidant activity of some selected traditional Indian medicinal plants. Indian J. Pharm. Sci. 2011, 73, 146–151. [Google Scholar] [CrossRef] [PubMed]
- Singleton, V.L.; Rossi, J.A. Colorimetry of total phenolics with phosphomolybdic-phosphotungstic acid reagents. Am. J. Enol. Vitic. 1965, 16, 144–158. [Google Scholar] [CrossRef]
- Cizeikiene, D.; Juodeikiene, G.; Paskevicius, A.; Bartkiene, E. Antimicrobial activity of lactic acid bacteria against pathogenic and spoilage microorganisms isolated from food and their control in wheat bread. Food Control 2013, 31, 539–545. [Google Scholar] [CrossRef]
- Nisa, Z.-U.; Rehman, S.-U.; Huma, N.; Shahid, M. Impact of mixed lactic acid bacterial (LAB) culture on flavoring profile and quality attributes of spring wheat sourdough bread. Pak. J. Agric. Sci. 2016, 53, 225–231. [Google Scholar]
- Hansen, Å. Sourdough bread. In Handbook of Plant-Based Fermented Food and Beverage Technology; Hui, Y.H., Özgül Evranuz, E., Eds.; CRC Press: Boca Raton, FL, USA, 2012; pp. 493–516. [Google Scholar]
- Katina, K.; Sauri, M.; Alakomi, H.-L.; Mattila-Sandholm, T. Potential of lactic acid bacteria to inhibit rope spoilage in wheat sourdough bread. LWT 2002, 35, 38–45. [Google Scholar] [CrossRef]
- Robert, H.; Gabriel, V.; Lefebvre, D.; Rabier, P.; Vayssier, Y.; Fontagne-Faucher, C. Study of the behavior of Lactobacillus plantarum and Leuconostoc starters during a complete wheat sourdough bread making process. LWT 2005, 39, 256–265. [Google Scholar] [CrossRef]
- Songré-Ouattara, L.T.; Mouquet-Rivier, C.; Icard-Vernière, C.; Humblot, C.; Diawara, B.; Guyot, J.P. Enzyme activities of lactic acid bacteria from a pearl millet fermented Gruel (Ben-Saalga) of functional interest in nutrition. Int. J. Food Microbiol. 2008, 128, 395–400. [Google Scholar] [CrossRef]
- Sanz-Penella, J.M.; Tamayo-Ramos, J.A.; Sanz, Y.; Haros, M. Phytate reduction in bran-enriched bread by phytase-producing bifidobacteria. J. Agric. Food Chem. 2009, 57, 10239–10244. [Google Scholar] [CrossRef]
- Castro-Alba, V.; Lazarte, C.E.; Perez-Rea, D.; Carlsson, N.G.; Almgren, A.; Bergenståhl, B.; Granfeldt, Y. Fermentation of pseudocereals quinoa, canihua, and amaranth to improve mineral accessibility through degradation of phytate. J. Sci. Food Agric. 2019, 99, 5239–5248. [Google Scholar] [CrossRef]
- Nuobariene, L.; Cizeikiene, D.; Gradzeviciute, E.; Hansen, Å.S.; Rasmussen, S.K.; Juodeikiene, G.; Vogensen, F.K. Phytase-active lactic acid bacteria from sourdoughs: Isolation and identification. Int. J. Food Microbiol. 2015, 63, 766–772. [Google Scholar] [CrossRef]
- Fernández, M.; Martín, A.; Benito, M.J.; Casquete, R.; Recio, I.; Córdoba, M.D.G. Influence of starter cultures on the generation of antioxidant nitrogen compounds in Iberian dry-fermented sausages. Int. J. Food Sci. Technol. 2016, 51, 435–443. [Google Scholar] [CrossRef]
- Martínez-Anaya, M.A. Enzymes and bread flavor. J. Agric. Food Chem. 1996, 44, 2469–2480. [Google Scholar] [CrossRef]
- Dallagnol, A.M.; Pescuma, M.; De Valdez, G.F.; Rollán, G. Fermentation of quinoa and wheat slurries by Lactobacillus plantarum CRL 778: Proteolytic activity. Appl. Microbiol. Biotechnol. 2013, 97, 3129–3140. [Google Scholar] [CrossRef] [PubMed]
- Matthews, A.; Jiranek, V. Lactic Acid Bacteria as a Potential Source of Enzymes for use in vinification. Appl. Environ. Microbiol. 2004, 70, 5715–5731. [Google Scholar] [CrossRef]
- Yoon, Y.; Lee, J. Verification of biological activities and tyrosinase inhibition of ethanol extracts from hemp seed (Cannabis sativa L.) fermented with lactic acid bacteria. J. Life Sci. 2018, 28, 688–696. [Google Scholar]
- Aloo, S.O.; Park, S.; Oh, D.H. Impacts of germination and lactic acid bacteria fermentation on anti-nutrients, bioactive compounds, and selected functional properties of industrial hempseed (Cannabis sativa L.). Food Chem. 2023, 428, 136722. [Google Scholar] [CrossRef]
- Rizzello, C.G.; Gobbetti, M. Improving the antioxidant properties of quinoa flour through fermentation with selected autochthonous lactic acid bacteria. Int. J. Food Microbiol. 2017, 24, 252–261. [Google Scholar] [CrossRef]
- Ayyash, M.; Johnson, S.K.; Liu, S.; Mesmari, N.; Dahmani, S.; Al Dhaheri, A.S.; Kizhakkayil, J. In vitro investigation of bioactivities of solid-state fermented lupin, quinoa and wheat using Lactobacillus spp. Food Chem. 2019, 275, 50–58. [Google Scholar] [CrossRef]
- Krungleviciute, V.; Maknickiene, Z. Design of lupin seeds lactic acid fermentation—Changes of digestibility, amino acid profile and antioxidant activity. Vet. Med. Zoot. 2016, 73, 47–53. [Google Scholar]
- Ibrahim, S.A.; Ayivi, R.D.; Zimmerman, T.; Siddiqui, S.A.; Altemimi, A.B.; Fidan, H.; Esatbeyoglu, T.; Bakhshayesh, R.V. Lactic acid bacteria as antimicrobial agents: Food safety and microbial food spoilage prevention. Foods 2021, 10, 3131. [Google Scholar] [CrossRef] [PubMed]
- Bakare, O.O.; Gokul, A.; Fadaka, A.O.; Wu, R.; Niekerk, L.A.; Barker, A.M.; Keyster, M.; Klein, A. Plant Antimicrobial Peptides (PAMPs): Features, applications, production, expression, and challenges. Molecules 2022, 27, 3703. [Google Scholar] [CrossRef] [PubMed]
- Kulaeva, O.; Kliukova, M.; Afonin, A.; Sulima, A.; Zhukov, V.; Tikhonovich, I. The role of plant antimicrobial peptides (AMPs) in response to biotic and abiotic environmental factors. Biol. Commun. 2020, 65, 187–199. [Google Scholar] [CrossRef]
- Tam, J.P.; Wang, S.; Wong, K.H.; Tan, W.L. Antimicrobial peptides from plants. Pharmaceuticals 2015, 8, 711–757. [Google Scholar] [CrossRef] [PubMed]
- Rivero-Pino, F.; Leon, M.J.; Millan-Linares, M.C.; Montserrat-de la Paz, S. Antimicrobial plant-derived peptides obtained by enzymatic hydrolysis and fermentation as components to improve current food systems. Trends Food Sci. Technol. 2023, 135, 32–42. [Google Scholar] [CrossRef]
- Sharma, P.; Kaur, J.; Sharma, G.; Kashyap, P. Plant derived antimicrobial peptides: Mechanism of target, isolation techniques, sources and pharmaceutical applications. J. Food Biochem. 2022, 46, 1–22. [Google Scholar] [CrossRef]
- Yekta, M.; Mousavi Khaneghah, A. The antimicrobial and antioxidant properties of produced burgers with quinoa peptide-loaded nanoliposomes. J. Food Saf. 2019, 40, e12753. [Google Scholar] [CrossRef]
- Mudgil, P. Multi-Functional Bioactive Properties of Intact and Enzymatically Hydrolysed Quinoa and Amaranth Proteins. Lebensm. Wiss. Technol. 2019, 110, 207–213. [Google Scholar] [CrossRef]
- Zou, T.-B.; He, T.-P.; Li, H.-B.; Tang, H.-W.; Xia, E.-Q. The Structure-Activity Relationship of the Antioxidant Peptides from Natural Proteins. Molecules 2016, 21, 72. [Google Scholar] [CrossRef]
- Girgih, A.T.; Udenigwe, C.C.; Aluko, R.E. In vitro antioxidant properties of hemp seed (Cannabis sativa L.) protein hydrolysate fractions. J. Am. Oil Chem. Soc. 2011, 88, 381–389. [Google Scholar] [CrossRef]
- Kim, S.Y.; Je, J.Y.; Kim, S.K. Purification and characterization of antioxidant peptide from hoki (Johnius belengerri) frame protein by gastrointestinal digestion. J. Nutr. Biochem. 2007, 18, 31–38. [Google Scholar] [CrossRef] [PubMed]
- Aluko, R.E. Antihypertensive properties of plant-derived inhibitors of angiotensin I converting enzyme activity: A review. Recent Prog. Med. Plants 2008, 22, 541–561. [Google Scholar]
- Udenigwe, C.C.; Lu, Y.L.; Han, C.H.; Hou, W.C.; Aluko, R.E. Flaxseed protein-derived peptide fractions: Antioxidant properties and inhibition of lipopolysaccharide-induced nitric oxide production in murine macrophages. Food Chem. 2009, 116, 277–284. [Google Scholar] [CrossRef]
- Pena-Ramos, E.A.; Xiong, Y.L. Antioxidant activity of soy protein hydrolysates in a liposomal system. J. Food Sci. 2004, 67, 2952–2959. [Google Scholar] [CrossRef]
- Irakli, M.; Cook, C.M. Effect of genotype and growing year on the nutritional, phytochemical, and antioxidant properties of industrial hemp (Cannabis sativa L.) seeds. Antioxidants 2019, 8, 491. [Google Scholar] [CrossRef]
- Garcia-Mora, P.; Frias, J.; Peñas, E.; Zieliński, H.; Giménez-Bastida, J.A.; Wiczkowski, W.; Zielińska, D.; Martínez-Villaluenga, C. Simultaneous release of peptides and phenolics with antioxidant, ACE-inhibitory and anti-inflammatory activities from Pinto bean (Phaseolus vulgaris L. var. Pinto) proteins by subtilisins. J. Funct. Foods 2015, 18, 319–332. [Google Scholar] [CrossRef]
- Chanput, W.; Theerakulkait, C.; Nakai, S. Antioxidative properties of partially purified barley hordein, rice bran protein fractions and their hydrolysates. J. Cereal Sci. 2009, 49, 422–428. [Google Scholar] [CrossRef]
Disclaimer/Publisher’s Note: The statements, opinions and data contained in all publications are solely those of the individual author(s) and contributor(s) and not of MDPI and/or the editor(s). MDPI and/or the editor(s) disclaim responsibility for any injury to people or property resulting from any ideas, methods, instructions or products referred to in the content. |
© 2024 by the authors. Licensee MDPI, Basel, Switzerland. This article is an open access article distributed under the terms and conditions of the Creative Commons Attribution (CC BY) license (https://creativecommons.org/licenses/by/4.0/).